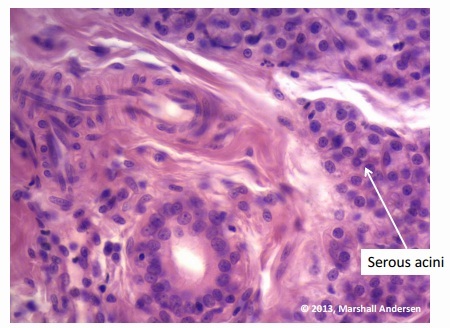
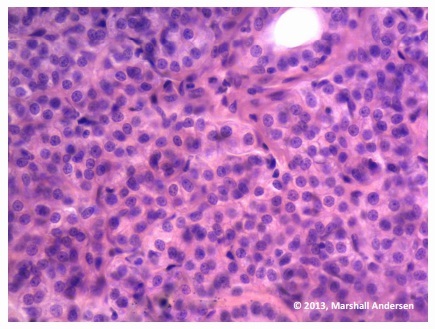
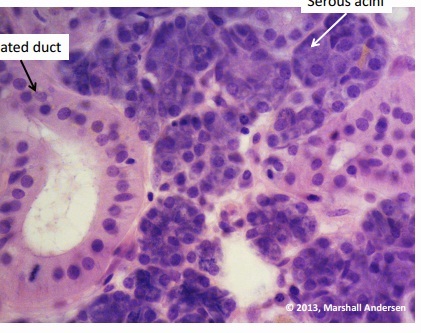

White Fiberous CT

Loose Areolar Tissue

Areolar CT

Elastic CT

Elastic CT

Adipose CT

Adipose

embryonic tissue

Dense Regular CT

Reticular and Elastic CT

muscle and tendon tissue

Brown fat
Parotid
Parotid

Sublingual

Sublingual

Submandibular
submandibular

Submandibular

Submandibular

Fibrocyte

Macrophage

Mast Cell

Plasma Cell